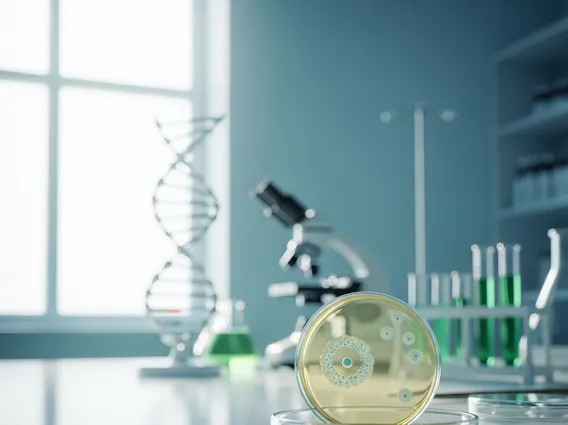

Measurable Disease
Measurable Disease is a critical concept in oncology and clinical research, defining the presence of cancer that can be accurately measured and monitored over time. This allows clinicians to evaluate treatment effectiveness and disease progression.
Key Takeaways
- Measurable Disease refers to cancer lesions that can be precisely measured by imaging or physical examination.
- It is a fundamental criterion for patient enrollment in many cancer clinical trials.
- Assessment involves standardized methods like RECIST criteria to ensure consistency.
- Regular evaluation of measurable lesions helps determine treatment response and disease progression.
- Accurate measurement is vital for evaluating new therapies and improving patient outcomes.
What is Measurable Disease?
The term Measurable Disease refers to a tumor or lesion that can be accurately measured in its greatest dimension, typically 10 mm or more, using imaging techniques such as CT scans, MRI, or physical examination. This precise measurement is crucial for tracking the disease’s response to treatment or its progression. A clear measurable disease definition is essential in oncology to standardize how cancer is evaluated across different clinical settings and research studies. Lesions that are too small, ill-defined, or located in areas difficult to measure consistently are considered non-measurable. The ability to quantify tumor size allows healthcare professionals to objectively assess changes over time, providing vital information for treatment planning and prognosis, and guiding critical decisions about therapeutic interventions.
Assessing Measurable Disease in Clinical Trials
In clinical trials, the assessment of measurable disease is a cornerstone for evaluating the efficacy of new cancer therapies. Standardized criteria are employed to ensure consistency and comparability across different studies and institutions. The most widely adopted criteria are the Response Evaluation Criteria in Solid Tumors (RECIST), which provide specific guidelines for identifying, measuring, and tracking target lesions. These criteria define what constitutes a measurable lesion and how changes in its size are interpreted as complete response, partial response, stable disease, or progressive disease. For a lesion to be considered measurable under RECIST, it must typically have a longest diameter of at least 10 mm when assessed by CT, MRI, or calipers, or 20 mm for chest X-ray. This rigorous approach is crucial for evaluating new treatments and ensuring reliable data for drug development.
The process of assessing measurable disease in clinical trials involves several critical steps to ensure accuracy and consistency:
- Baseline Assessment: Before any treatment begins, all identified lesions are thoroughly documented and measured to establish a precise starting point. This initial assessment is vital for subsequent comparisons.
- Target Lesion Selection: A limited number of representative lesions (typically up to five per organ, and no more than two per organ, or a maximum of five total) are carefully chosen as “target lesions” for consistent follow-up measurements. These are selected based on their size, clear measurability, and how well they represent the overall disease burden.
- Non-Target Lesion Monitoring: While not precisely measured, other non-target lesions are also monitored for their presence or disappearance, contributing to the overall assessment of treatment response.
- Regular Re-evaluation: Throughout the trial, these target lesions are re-measured at predetermined intervals using the exact same imaging modality and technique as the baseline. This consistency minimizes variability in measurements.
- Response Evaluation: Changes in the sum of the longest diameters of the target lesions, combined with observations of non-target lesions, are then used to classify the patient’s response to treatment according to RECIST guidelines.
This systematic evaluation allows researchers to objectively determine if a new therapy is shrinking tumors, stabilizing the disease, or if the cancer is progressing. The consistent application of these criteria, as highlighted by numerous studies in oncology, is fundamental for generating robust evidence that can inform clinical practice and regulatory decisions. Accurate assessment of measurable disease directly impacts the approval of new drugs and the advancement of cancer care.